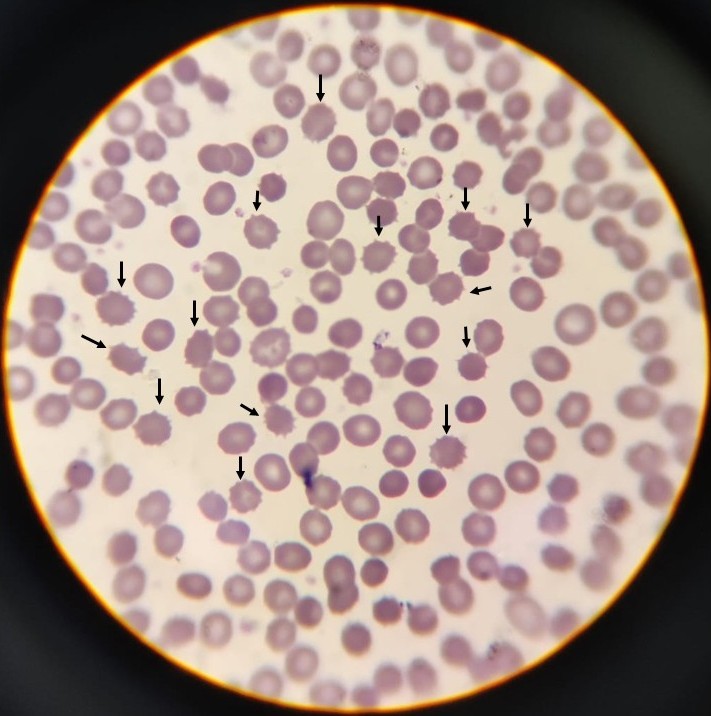

Category: Choreas (Non-Huntington's Disease)
Objective: This is the first reported case of choreoacanthocytosis with molecular confirmation in northern Mexico, which also presented a previously unreported variant in genetic databases.
Background: Choreoacanthocytosis (ChAc) is a rare neurodegenerative disorder associated with mutations in the VPS13A gene, which encodes the chorein protein. Clinically, it is characterized by chorea, dystonia, gait disturbances, cognitive impairment, and acanthocytosis in peripheral blood.(1) The estimated prevalence is 1 in 1,000,000 individuals.(2)
Method:
Case report.
Results: A 27-year-old woman, born to non-consanguineous parents, presented with a three-year history of dysarthria, dysphagia, generalized choreiform movements, orofacial and lingual dyskinesia, and a dystonic disorder affecting the right lower limb.
On physical examination, she exhibited motor impersistence, generalized choreiform movements, distal dystonia in the right leg, and cognitive impairment (MoCA test: 19 points). Brain MRI showed atrophy of the head of the caudate nucleus(FH/CC = 1.44; CC/IT = 0.18)(Figure 1).
Serum ceruloplasmin and heavy metal levels were normal, and acanthocytes were detected in the peripheral blood smear(Figure 2). Next-generation sequencing (NGS) identified two heterozygous variants in VPS13A: c.3556_3557dup and c.6096-3C>A, the latter being a novel, previously unreported variant.
Conclusion: This is the first reported case of ChAc with molecular confirmation in northern Mexico, which also revealed a novel variant. A literature review identified only two previously reported cases of ChAc in Mexico, in which the mutation reported was c.3556_3557dup. (3, 4)
Figure 1
Figure 2
References: 1.- Spieler D, Velayos-Baeza A, Muhlback A, et al. Identification of two compound heterozygous VPS13A large deletions in chorea-acanthocytosis only by protein and quantitative DNA analysis. Mol Genet Genomic Med. 2020;8(9):e1179. doi:10.1002/mgg3.1179.
2.- Walker RH, Peikert K, Jung HH, et al. Neuroacanthocytosis Syndromes: The Clinical Perspective. Contact (Thousand Oaks). 2023;6:25152564231210339. doi:10.1177/25152564231210339
3.- Ruiz-Sandoval JL, García-Navarro V, Chiquete E, et al. Choreoacanthocytosis in a Mexican Family. Arch Neurol. 2007;64(11):1661-1664. doi:10.1001/archneur.64.11.1661.
4.- Alonso ME, Teixeira F, Jimenez G, et al. Chorea-acanthocytosis: report of a family and neuropathological study of two cases. Can J Neurol Sci. 1989;16(4):426-431. doi:10.1017/s0317167100029516
To cite this abstract in AMA style:
L. Hernández Salomón, S. Flores Casas, J. Mejía Chávez, S. Murillo Quintana, D. Sánchez Galván. Novel heterozygous variant in VPS13A: First case report of choreoacanthocytosis in northern México [abstract]. Mov Disord. 2025; 40 (suppl 1). https://www.mdsabstracts.org/abstract/novel-heterozygous-variant-in-vps13a-first-case-report-of-choreoacanthocytosis-in-northern-mexico/. Accessed May 26, 2026.« Back to 2025 International Congress
MDS Abstracts - https://www.mdsabstracts.org/abstract/novel-heterozygous-variant-in-vps13a-first-case-report-of-choreoacanthocytosis-in-northern-mexico/